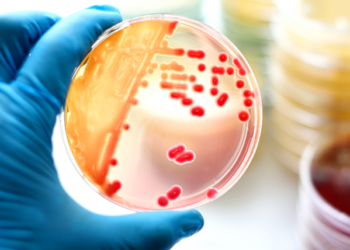
MİKROPLARDAN NASIL KORUNULUR

Pubg Mobile Bedava UC Alma
16 Kasım 2024
Pubg Mobile Bedava Hesap Alma
16 Temmuz 2024
Pubg Mobile Bedava Firavun Seti Alma
16 Temmuz 2024
Melek Azad İfşa Olayı, Melek Azad Kimdir?
24 Ağustos 2022
Diyet Yapmadan Zayıflayanlar Ne Yapıyor?
12 Şubat 2026
Kilo Vermek Neden Bu Kadar Zor?
12 Şubat 2026
Zayıflamak Sandığından Daha Kolay Olabilir?
12 Şubat 2026
Herkesin Bilmediği Kilo Verme Tüyoları
12 Şubat 2026